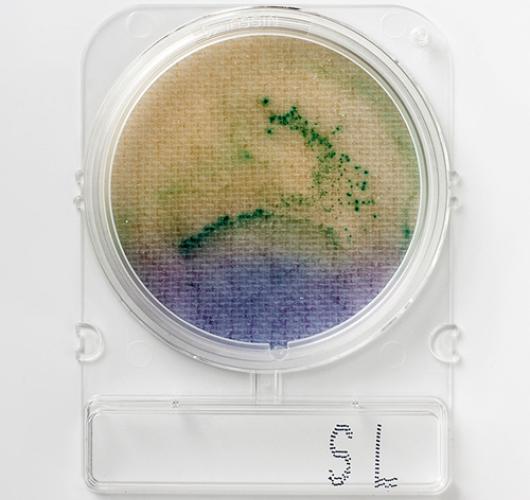

Подложки сальмонелла - Compact Dry SL
Подложки сальмонелла - Compact Dry SL
Тест на присудствие/отсудствие
Как в пищевых продуктах, так и в образцах окружающей среды анализ на сальмонеллу является обязательным.
Состав основан на различных окончательных тестах на подвижность бактерий и специфическую хромогенную окраску.
Первым признаком присутствия сальмонеллы является сине-фиолетовая среда, которая становится желтой из-за действия лизиндекарбоксилазы сальмонеллы.
По мере того как подвижная сальмонелла распространяется по поверхности, среда синего/фиолетового цвета становится желтой, отражая подвижность сальмонеллы.
Позеленение поверхности среды происходит в результате взаимодействия хромогенного субстрата, входящего в состав среды, со специфическим ферментом сальмонелл.
Черно-зеленые колонии указывают на продукцию сероводорода сальмонеллами. Если желтый, черный и зеленый цвета наблюдаются вместе в среде всех упомянутых реакций, можно сделать вывод, что развилась сальмонелла.
При очень высокой концентрации сальмонеллы образуются плотные зелено-черные колонии, а вся среда сальмонеллы становится желтой.
Цвет колоний: Желтый+Зеленый+Черный
(При свойстве лизиндекарбоксилазы фиолетовый слой становится желтым после подщелачивания среды. Зеленые колонии образуются при разложении хромогенного субстрата. Продуцирующие сероводород образуют черные колонии.)
Температура и время инкубации:
Предварительное обогащение: 35–37°C/24 часа.
Основная инкубация: 41–42°C/24 часа.
Срок хранения: 12-18 месяцев при 5-30°С.